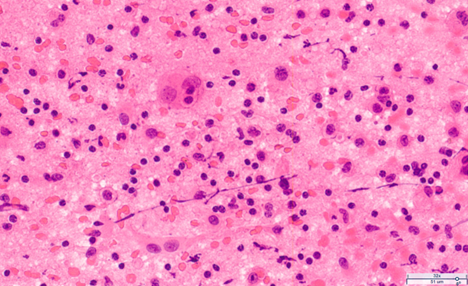

|
Case of the Month: November 2025 Title: A female in her 5th decade with multiple extra-axial masses. Authors: Simmi Patel, M.D. and Scott Kulich, M.D. PhD Institution: University of Pittsburgh Clinical History: A female in her 5th decade with a past medical history of migraines presented to the emergency department with worsening of chronic left-sided headaches associated with nausea, photophobia, phonophobia, and vision changes. MRI of the brain demonstrated multiple enhancing extra-axial lesions measuring up to 1.5 cm in greatest dimension (Figure 1). The patient underwent craniotomy for biopsy and excision.
Figure 1: MRI of the brain showing an enhancing extra-axial mass (highlighted in red). Microscopic examination: Intraoperative H&E cytologic preparations demonstrated a polymorphous collection of inflammatory cells, some of which contained voluminous cytoplasm (Figure 2).
Figure 2: H&E-stained cytologic preparations. H&E-stained sections of formalin fixed paraffin-embedded tissue demonstrate dense fibroconnective tissue involved by a mixed inflammatory cell infiltrate which focally contains clusters of foamy macrophages and larger cells, some of which contain intracytoplasmic inflammatory cells (Figure 3A-3C). Immunohistochemical stains show that these larger cells are positive for S100, cyclin D1, and Oct2 (Figure 3D-3F). In addition, the larger cells are strongly and diffusely positive for CD163 with factor XIIIa and LCA stains highlighting a subset of these larger cells while stains for CD1a, langerin, BRAF V600E, ALK1, CD15, CD30, pax5, CD20, EBER, and CD3 are negative in these larger cells. Figure 3: H&E and immunohistochemically-stained sections (H&E, A-C: H&E-stained sections; D- S100, E- Cyclin D1, and F- OCT 2. (magnification as indicated by scale bars). |